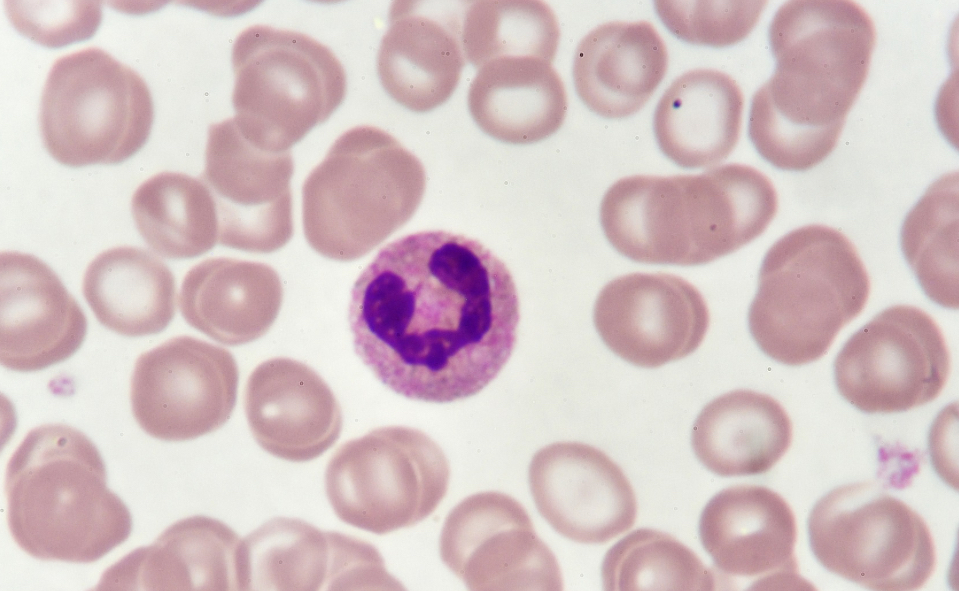
knowt flashcard image
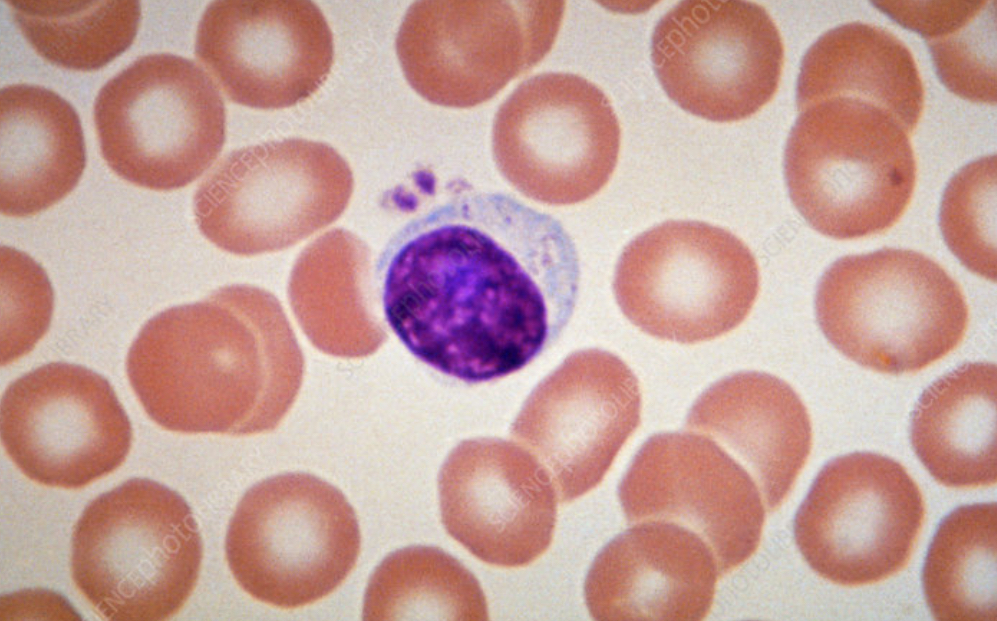
knowt flashcard image

Biology Need to Know: Gaps in Knowledge
0.0(0)
Card Sorting
1/306
Last updated 4:00 PM on 4/26/23
Name | Mastery | Learn | Test | Matching | Spaced | Call with Kai |
|---|
No analytics yet
Send a link to your students to track their progress
307 Terms
1
New cards
Tidal volume
The volume of air in each breath
2
New cards
Volume in tidal volume
0\.4 dm³
3
New cards
Vital Capacity
The maximum volume of air that can be breathe in or out
4
New cards
Breathing rate
How many breaths are taken per unit time (usually minute)
5
New cards
Oxygen uptake
The rate at which a person uses up oxygen (usually dm³ per minute)
6
New cards
Light microscope maximum resolution
0\.2 um
7
New cards
Light microscope maximum magnification
X 1500
8
New cards
Light microscope image type
2D, colour
9
New cards
Advantage of light microscopes
Can see at different depths
10
New cards
Disadvantages of light microscopes
Not very high resolution or magnification
11
New cards
Scanning electron microscope maximum resolution
0\.002 um
12
New cards
Scanning Electron Microscope maximum magnification
X 500 000
13
New cards
S.E.M image type
3D
14
New cards
Advantage of S.E.M
Shows the surface of the specimen
15
New cards
Disadvantages of S.E.M
Lower resolution than T.E.M
16
New cards
Transmission electron microscope maximum resolution
0\.0002um
17
New cards
T.E.M maximum magnification
X 1 000 000
18
New cards
T.E.M image type
2D
19
New cards
T.E.M advantages
High resolutions so can look at organelle structures in detail
20
New cards
T.E.M disadvantages
Specimen needs to be very thinly sliced
21
New cards
Monocyte image

22
New cards
Monocyte role
Biggest white blood cell and a phagocyte
23
New cards
Identifiable features of monocytes
Kidney shaped nucleus and non-grainy cytoplasm.
24
New cards
Neutrophil image
25
New cards
Neutrophil identifiable features
Multi-lobed nucleus and grainy cytoplasm
26
New cards
Lymphocyte image
27
New cards
Lymphocyte identifiable features
Nucleus dominates most of the cell, non-grainy cytoplasm. Lymphocyte are much smaller than neutrophils
28
New cards
Cellulose structure image

29
New cards
Which monomer of glucose does cellulose use
β glucose
30
New cards
Which bonds does cellulose have
β glucose 1,4 glycosidic bonds
31
New cards
Properties of cellulose:
* insoluble in water
* High tensile strength, due to the alternate arrangement of glucose molecules
* Soluble in organic solvents
* High tensile strength, due to the alternate arrangement of glucose molecules
* Soluble in organic solvents
32
New cards
What organelle is cellulose most commonly found in?
Plant cell walls
33
New cards
Starch structure image

34
New cards
What two monomers make up the starch polymer
Amylose and amylopectin
35
New cards
What is starch found as in plant cells
Granules
36
New cards
What is the purpose of starch
As a glucose storage molecule for plants
37
New cards
Amylopectin structure image

38
New cards
Amylopectin structure
Branched
39
New cards
Amylopectin bonds
1,4 and 1,6 glycosidic bonds
40
New cards
Amylose structure image

41
New cards
Amylose structure
Unbranched
42
New cards
Amylose bonds
Only 1,4 glycosidic bonds
43
New cards
α glucose image

44
New cards
β glucose image

45
New cards
Glycogen structure
Branched
46
New cards
Glycogen bonds
α 1,4 glycosidic bonds and α 1,6 glycosidic bonds
47
New cards
Which monomer of glucose is used for glycogen
Alpha glucose
48
New cards
Callose image structure

49
New cards
Callose monomer
β glucose
50
New cards
Callose bonds
β 1,3 glycosidic bonds
51
New cards
Callose function
Deposited at plasmodesmata in times of stress to prevent pathogens from entering cells
52
New cards
Thin filaments within a myofibril are made of …. molecules
Actin
53
New cards
Actin molecules are ………….. molecules
Globular protein
54
New cards
Test for proteins
Biuret Test
55
New cards
Biuret test positive result
Colour change from blue to lilac/purple
56
New cards
Steps for biuret test
* are a liquid solution of the sample and treat with KOH to make the solution alkaline
* Add bieuret reagent
* Add bieuret reagent
57
New cards
Test for lipids
Emulsion test
58
New cards
Emulsion test positive result
Milky emulsion will form on addition of water
59
New cards
Emulsion test steps
* dissolve in ethanol, shake to mix and then add water
60
New cards
Test for starch
Iodine
61
New cards
Iodine test positive result
Organelle/brown to blue/black
62
New cards
Name a non-reducing disaccharide
Sucrose
63
New cards
What monomers is sucrose made of
Alpha Glucose and fructose
64
New cards
Lactose monomers
Beta glucose and galactose
65
New cards
lactose glycosidic bond
1,4 glycosidic bond between galactose and glucose
66
New cards
Sucrose glycosidic bond
Alpha -1 beta- glycosidic bond
67
New cards
Maltose monomers
Glucose and glucose
68
New cards
Maltose enzyme
maltase
69
New cards
Trehalose monomers
two alpha glucose molecules joined by a 1,1 glycosidic bond
70
New cards
Trehalose is found in …
Insect and fungi
71
New cards
Is Trehalose reducing or non-reducing
Non-reducing
72
New cards
What are plant cell walls made of?
Cellulose
73
New cards
Ribosome function
Site of protein translation
74
New cards
RER function
folds and processes proteins that have been made at the ribosomes
75
New cards
RER description
A system of membranes enclosing a fluid-filled space, the surface is covered with ribosomes.
76
New cards
SER function
Synthesises and processes lipids
77
New cards
SER description
Like RER but without ribosomes
78
New cards
Mitochondrion shape
Oval shaped with a double membrane
79
New cards
Golgi body function
Processes an packages new lipids and proteins as well as making lysosomes
80
New cards
Vesicle function
Transports substances in and out of cell via the plasma membrane and between organelles.
81
New cards
Centriole function
Involved with the separation of chromosomes during cell division.
82
New cards
Centriole description
Small, hollow cylinders made of microtubules.Found in animals cells but only some plant cells
83
New cards
What are cilia and flagella made from
Microtubules
84
New cards
Protein pathway
mRNA is transcribes → out of nuclear pore → ribosome on R.E.R → Golgi body
85
New cards
4 functions of the cytoskeleton
* support organelles and their positioning
* Help to strength the cell and maintain its shape
* Transport organelles and material within the cell
* Cell cause the cell to move
* Help to strength the cell and maintain its shape
* Transport organelles and material within the cell
* Cell cause the cell to move
86
New cards
Arrangement of microtubules in cilia
9 pairs around and 1 pair in the middle
87
New cards
Size of eukaryotic ribosomes
80S
88
New cards
Size of prokaryotic ribosomes
70S
89
New cards
Cell walls of fungi are made of
Chitin
90
New cards
Cell walls of plants are made of
Cellulose
91
New cards
Are prokaryote organelles membrane bound?
Prokaryotic organelles are not membrane bound
92
New cards
Magnification \=
Image size / object size
93
New cards
What unit must lengths be in when calculating magnification?
Doesn’t matter but all must be in the same unit
94
New cards
Mm to µm
X 1000
95
New cards
µm to nm
X 1000
96
New cards
Resolution is
How detailed the image is - or how well the microscope distinguishes between two pints that are close together.
97
New cards
Will increasing the magnification increase the resolution?
No
98
New cards
Light microscope maximum resolution
0.2µm
99
New cards
T.E.M maximum resolution
0\.0002 µm
100
New cards
Light microscope maximum magnification
X 1500